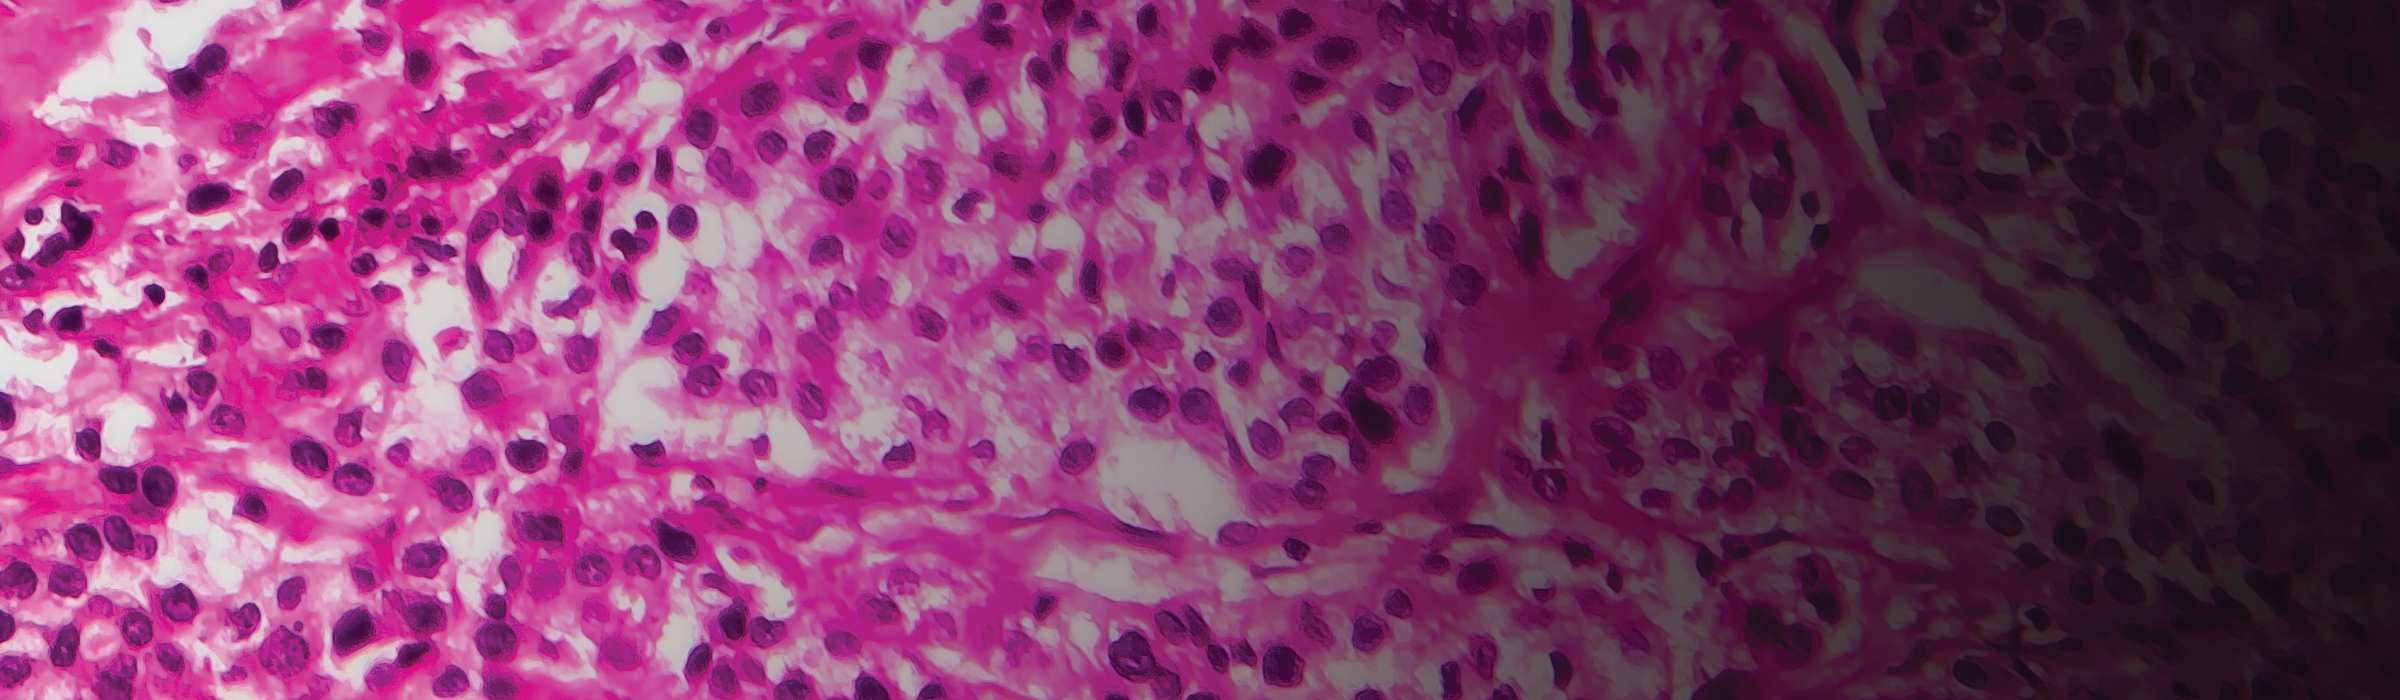
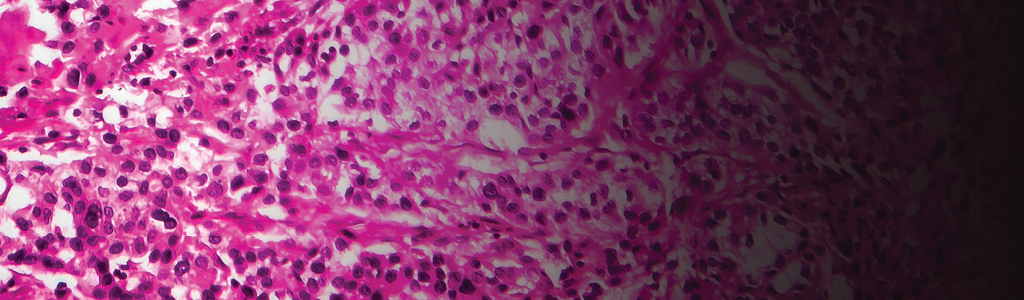
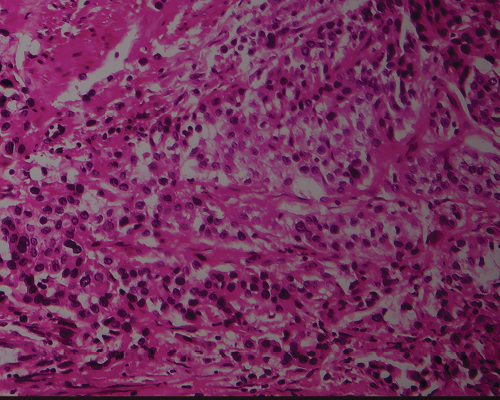

Introduction:
Applied Clinical Education (“Us” or “We”), which owns and runs this website, and its wholly owned subsidiaries values your privacy and recognizes the significance of privacy for personal information. We want you to understand what private information we collect about you, and how we use your private information. The nature of the information and services that we provide through our website requires that we collect and use information about you as more fully described below. In addition, Applied Clinical Education may use your private information to offer you additional information, products or services that match your areas of interest. Should you have any questions regarding this Privacy Statement (“Privacy Statement” “Privacy Policy” or “Policy”), please send an email to
cmezonesupport@appliedcme.com. By consenting to our Privacy Statement you are agreeing to the following.
This Privacy Statement covers the following topics:
- What we collect
- How we user private information
- Security and confidentiality
- Your rights
- Links to other websites
- Cookies
- Changes to Privacy Statement
- DMD Healthcare Communications Network
What We Collect:
We may collect the following information:
-
"Personal Information" – that is, information such as your full name, email address, mailing address and telephone number;
-
"Device Information" – that is, information about you or your activities (such as your Internet Protocol Address information about your browser and/or operating system), through which we do not attempt to identify you but through which it may be possible to identify you; and/or
-
Information related to customer surveys, promotions and/or offers that may be Personal Information and/or Device Information (e.g., preferences, demographics, interests, etc.).
We collect Personal Information from our online visitors only when voluntarily offered when you register for access to our site, which includes consenting to the collection of information. We may also collect Device Information from users of this Applied Clinical Education website. This Personal and Device Information may be obtained from third parties. If you have logged in to a password-protected part of our websites, we will also record your username.
How We Use Private Information:
We use the information described above to facilitate the effective operation of the Applied Clinical Education websites, to improve our websites and to measure overall use by viewers. The information we collect is aggregated into reports that enable us to monitor use and security. Aggregated use statistics and Device Information are used within Applied Clinical Education and may be shared with third parties. Personal Information, however, will not be shared. Applied Clinical Education does not otherwise make a practice of selling or supplying Personal or Device Information to others, unless we are required to do so by law or because it is pertinent to judicial, administrative or governmental investigations or proceedings.
We also use the information you provide through the registration process to supply you with the information and services you request, to communicate with you on matters relating to the website and your registration, to collect demographic information for future programs, and to provide you with information about related services. You may choose to disclose or not disclose the private information we request during the registration process. However, if you choose not to disclose the requested information, we may not be able to provide you with some or all of the information or services you request.
If you do not wish to receive certain communications from Applied Clinical Education, you have the ability to opt out by declining the service offered or informing us that you no longer wish to receive such communications. We will comply with your request unless such communications are required by law or necessary to protect our rights.
Besides using information to provide our services, Applied Clinical Education uses information maintained about you and other information obtained from your current and past activities to resolve disputes, troubleshoot problems and enforce our rights. At times, Applied Clinical Education may review the information of multiple users to identify problems or resolve disputes.
Security and Confidentiality:
We are committed to ensuring that your Personal Information is secure. To prevent unauthorized access or disclosure, we have put in place appropriate physical, electronic and managerial procedures to safeguard and secure the information we collect online. However, we accept no obligation to maintain the confidentiality of nonconfidential data such as feedback, questions, comments or ideas that you voluntarily provide to us (e.g., via the "Contact" tab or similar features on the Applied Clinical Education website). We reserve the right to use and disclose such nonconfidential information as we deem appropriate. By voluntarily submitting feedback to us, you consent to these terms.
Your Rights:
At any time, you may print a copy, or download or request a printed copy of this Privacy Policy. You may, at any time, request access to the personally identifiable information we have collected about you and may request corrections, updates or deletions to that information.
Please email your request to: cmezonesupport@appliedcme.com. Please state "Request/Remove/Change Personal Data" in the subject line of your email. Our response to such inquiries may be limited to information under our direct control.
Links to Other Websites:
This privacy policy applies only to information collected by Applied Clinical Education. Please note that some of the links on Applied Clinical Education websites connect to other, third-party websites. Once you leave any Applied Clinical Education website (whether through an advertisement, service, content or other link), be aware that any information you provide to, or that is collected by, third-party sites may be subject to the privacy policies of those sites, if any. It is the sole responsibility of such third parties to adhere to any applicable restrictions concerning the disclosure of your private information, and Applied Clinical Education shall not be liable for the wrongful use or disclosure of your private information by any third party.
Cookies:
When you visit the Applied Clinical Education website, we may use "cookies" and similar technologies to help us recognize and serve you better. Cookies are small files that contain information sent by a website that is saved on your computer's hard drive. A list of all cookies used on this website by category is set out below. When visiting the site, you will be asked to consent to the use of cookies. You may delete cookies from your computer or set your browser to reject cookies.
"Strictly Necessary" Cookies:
These cookies are essential to enable you to move around the website and use its features. Without these cookies, services you have asked for cannot be provided.
"Performance" Cookies:
These cookies collect information about how visitors use a website, for example which pages visitors go to most often and whether they get error messages from web pages. These cookies do not collect information that identifies a visitor. All information collected by these cookies is aggregated and therefore anonymous. It is only used to improve how a website works.
"Functionality" Cookies:
These cookies allow the website to remember choices you make (such as your username, language or the region you are in) and provide enhanced, more personal features. These cookies can also be used to remember changes you have made to text size, fonts and other parts of web pages that you can customize. They may also be used to provide services you have asked for, such as watching a video or commenting on a blog. The information these cookies collect is anonymous and they cannot track your browsing activity on other websites.
Changes to Privacy Statement:
Please note that this Privacy Statement may change from time to time. We will notify you of any material changes by posting a link on the home page of our websites labeled "Revised Privacy Statement." We will also indicate a revised Effective Date at the top of the Privacy Policy, and the changes in the Privacy Statement will not be effective until 30 days after first posting the revised version. Please check this Privacy Statement regularly.
Additional Information for California Consumers:
In accordance with the California Consumer Privacy Act (“CCPA”), the following applies to personal information collected from individuals residing in California and is effective as of January 1, 2020 and is in addition to the information set forth above.
Types of Personal Information Collected and Uses:
We may collect the information set forth in Section 2 of this Policy. We use the information we collect in accordance with Section 3 of this Policy.
Sale of Personal Information:
In accordance with Section 2 of this Policy, Applied Clinical Education does not otherwise make a practice of selling personal information to others. Furthermore, Applied Clinical Education: (a) has not sold any personal information to third parties for a business or commercial purpose in the preceding twelve months and (b) does not sell personal information of minors under 16 years of age.
Right to Request Information Collected and Deletion:
At any time, you may print a copy, or download or request a printed copy of this Privacy Policy. You may, at any time, request access to the personal information we have collected about you and may request corrections, updates or deletions to that information.
Please complete our online form, email your request to: cmezonesupport@appliedcme.com or call us toll free at 1-888-350-8855. If communicating with us via email please state "Request/Remove/Change Personal Data" in the subject line of your email. Please provide first and last name, email and mailing address previously provided to us. Our response to such inquiries may be limited to information under our direct control.
Designation of an Authorized Agent:
You may designate an authorized agent to make a request pursuant to the CCPA on your behalf. Please email your request to: cmezonesupport@appliedcme.com. Please state "Designation of an Authorized Agent for Personal Data" in the subject line of your email or call us toll free at 1-888-350-8855. We may ask you to provide additional information you previously provided so that we may verify you.
Contact Us:
If you have any questions related to this privacy policy or wish to access this Policy in an alternative format due to disability please contact us at cmezonesupport@appliedcme.com.
Exercise of Rights/Non-Discrimination:
Consumers have a right not to receive discriminatory treatment by us for the exercise of the privacy rights conferred by the CCPA.
DMD Healthcare Communications Network ℠ Privacy Statement:
This digital service participates in the DMD Healthcare Communications Network (the "Network"), and as such has implemented various technologies for universal registration/login among all Network member websites.
These technologies are managed by DMD Marketing Corp. ("DMD"), and may involve the collection, receipt and sharing of Personal Information with DMD, its clients and other Network members. If you would like to understand how this digital service’s participation in the Network affects your privacy, please click here:
http://usersupport.dmdconnects.com/PrivacyPolicy.htm
Please note that the Network registration/login system may differ from the registration/login used by this digital service for other products and services. To the extent that anything in this privacy policy conflicts with the policy of the Network technologies, the conflict will be resolved in favor of the policy applicable to the Network technologies.